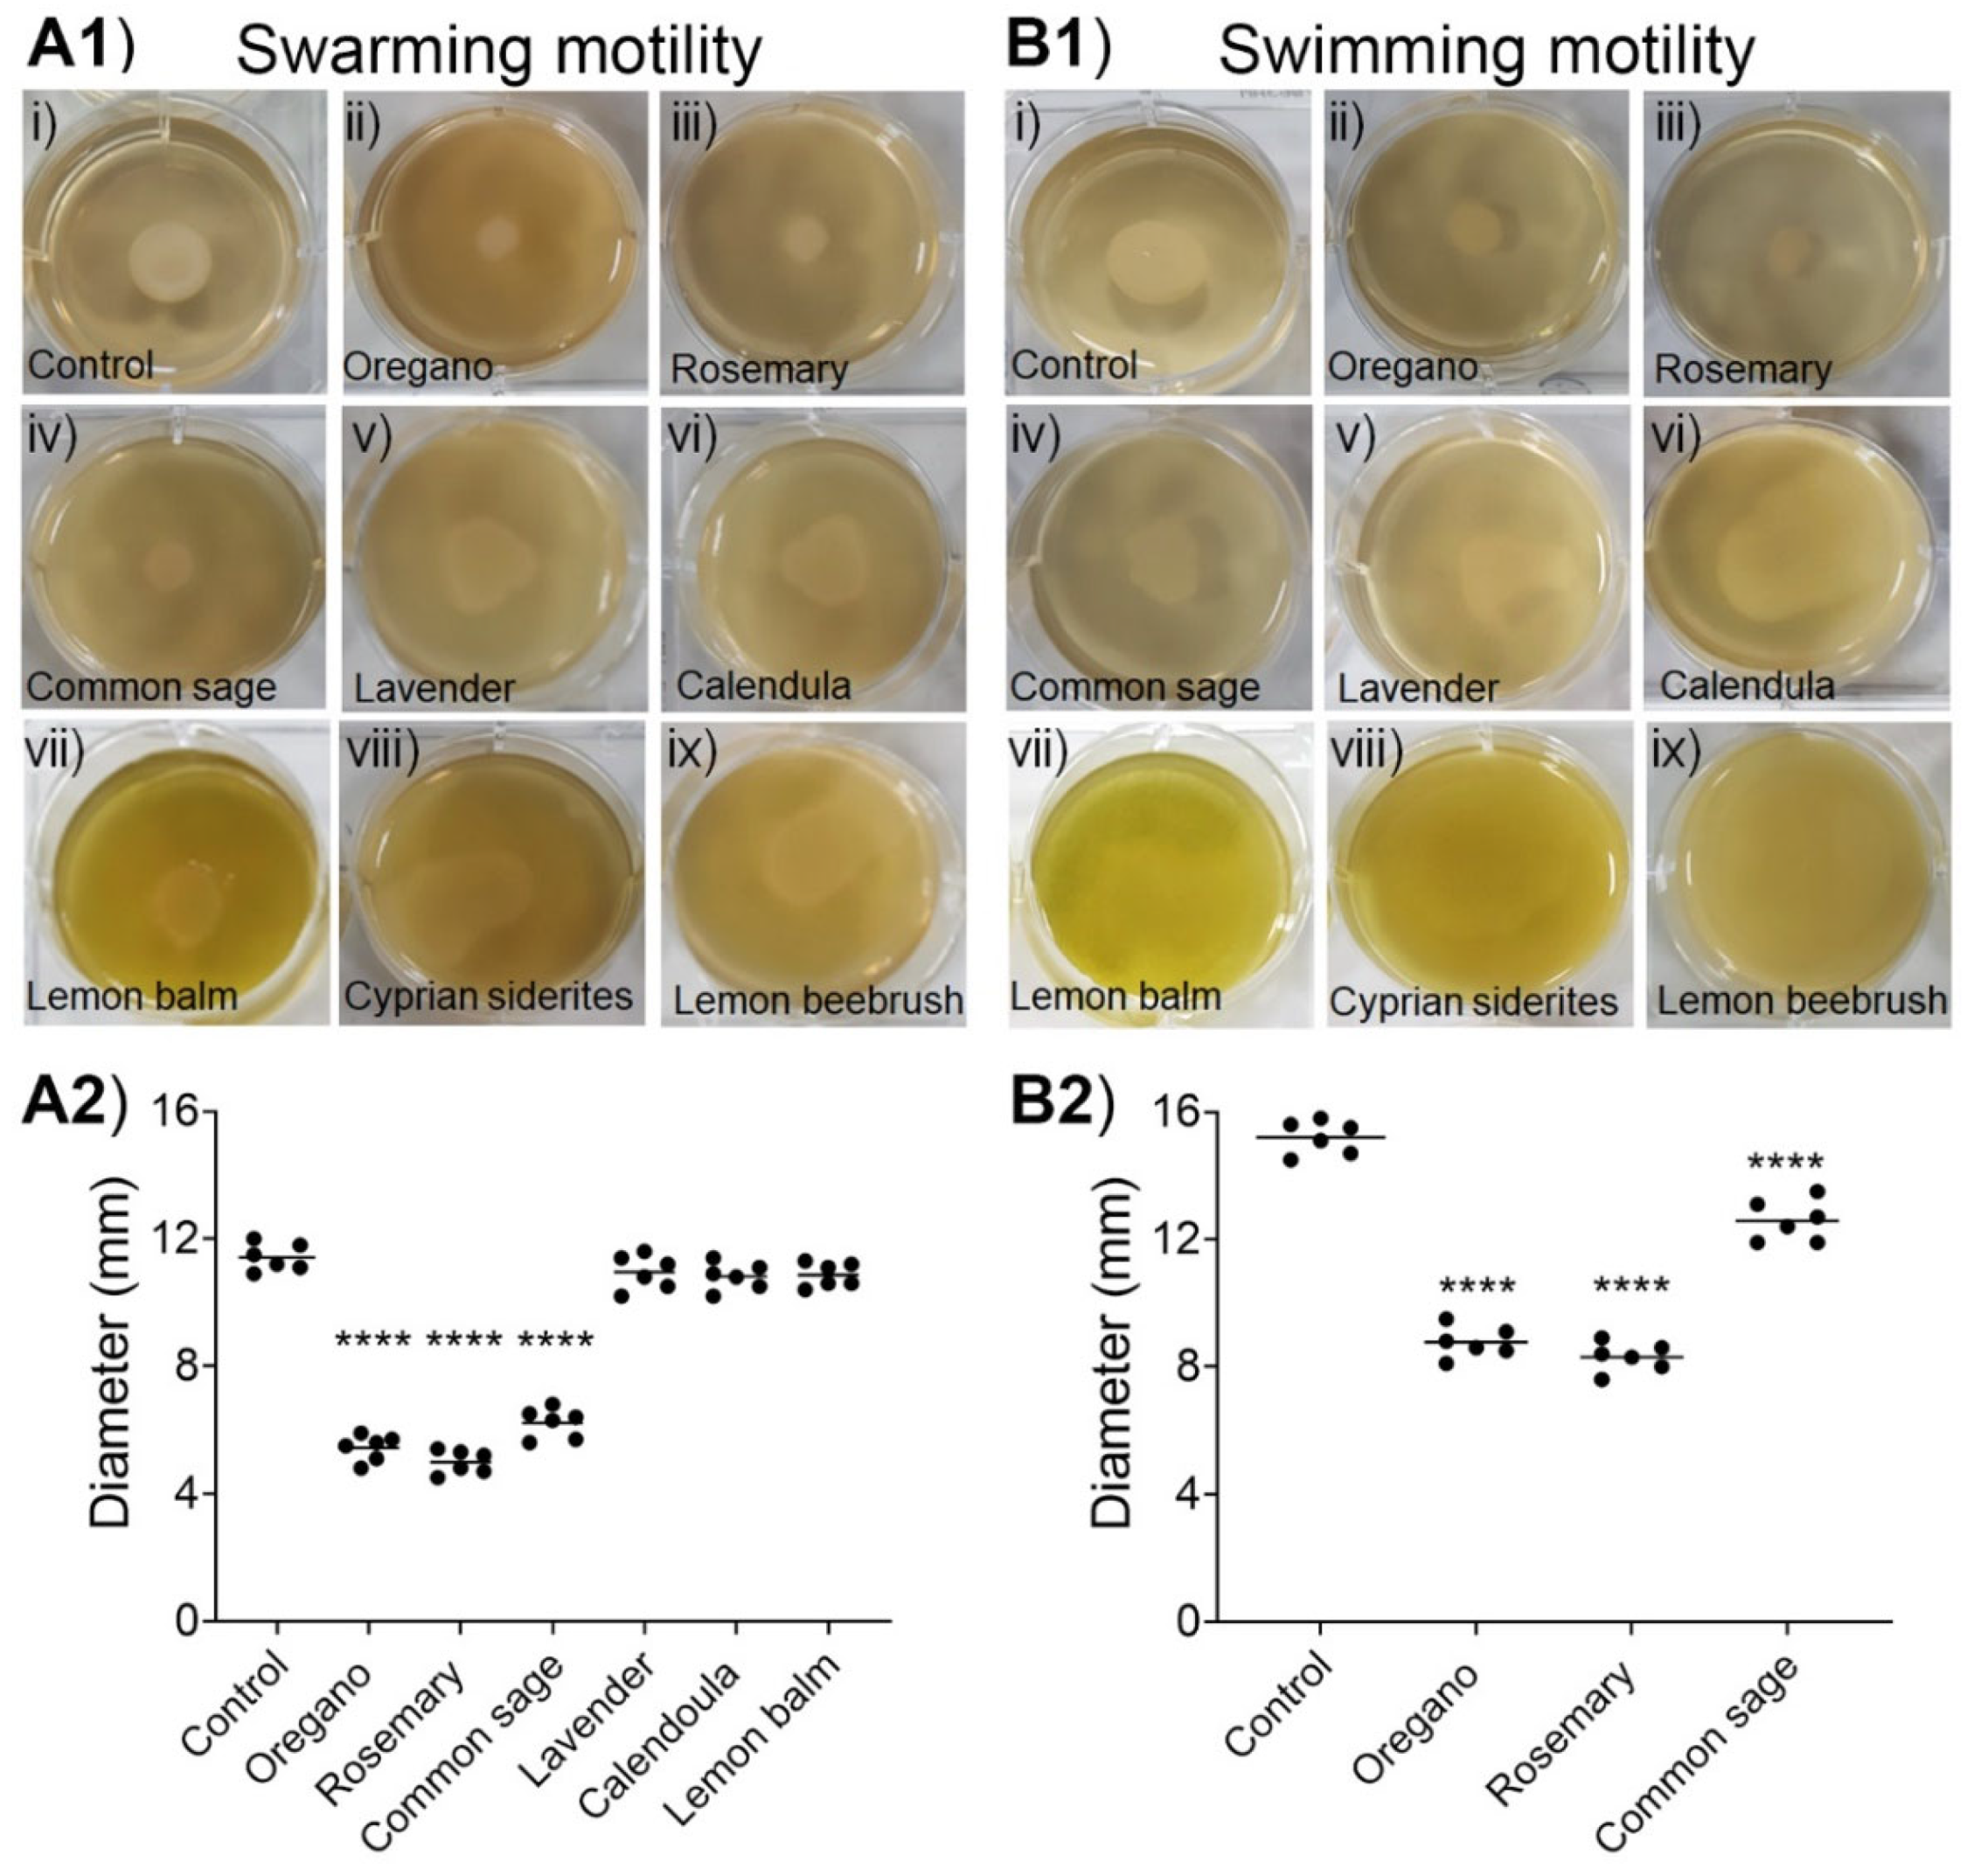
Plants 11 02632 g004 Plants 11 02632 g004

Anti-Quorum-Sensing Potential of Ethanolic Extracts of Aromatic Plants from the Flora of Cyprus
Abstract
1. Introduction
2. Results
2.1. Plant Material and Extraction of Active Compounds
2.2. Inhibition of AI-2 Activity by the Ethanolic Extracts
2.3. Effects of Plant Extracts on Biofilm Formation
2.4. Impacts of Phytochemicals on the Swarming and Swimming Motilities of E. coli MG 1655
2.5. Effects of Plant Extracts on the Growth of E. coli
2.6. Determination of the Composition of Ethanolic Extracts with the Highest Anti-Quorum-Sensing Activity by LC-MS
3. Discussion
4. Materials and Methods
4.1. Selection and Preparation of Plants
4.2. Extraction of Active Compounds from Plants
4.3. Bacterial Strains, Media, and Culture Conditions
4.4. Autoinducer-2 Bioassay
4.4.1. Preparation of Cell-Free Supernatants
4.4.2. Inhibition of AI-2 by the Ethanolic Extracts
4.5. Inhibition of Biofilm Formation
4.6. Motility Assays
4.7. Effects of Ethanolic Extracts on Bacterial Growth
4.8. Determination of the Composition of Ethanolic Extracts with the Highest Anti-Quorum-Sensing Activity by HPLC and ESI-MS
4.9. Statistical Analysis
5. Conclusions
Supplementary Materials
Author Contributions
Funding
Institutional Review Board Statement
Informed Consent Statement
Data Availability Statement
Acknowledgments
Conflicts of Interest
References
- Zaman, S.B.; Hussain, M.A.; Nye, R.; Mehta, V.; Mamun, K.T.; Hossain, N. A review on antibiotic resistance: Alarm bells are ringing. Cureus 2017, 9, e1403. [Google Scholar] [CrossRef] [PubMed]
- Durand, G.A.; Raoult, D.; Dubourg, G. Antibiotic discovery: History, methods and perspectives. Int. J. Antimicrob. Agents 2019, 53, 371–382. [Google Scholar] [CrossRef] [PubMed]
- Lewis, K. Platforms for antibiotic discovery. Nat. Rev. Drug Discov. 2013, 12, 371–387. [Google Scholar] [CrossRef]
- de Kraker, M.E.A.; Stewardson, A.J.; Harbarth, S. Will 10 million people die a year due to antimicrobial resistance by 2050? PLoS Med. 2016, 13, e1002184. [Google Scholar] [CrossRef]
- Hall, B.G. Predicting the evolution of antibiotic resistance genes. Nat. Rev. Microbiol. 2004, 2, 430. [Google Scholar] [CrossRef] [PubMed]
- Munita, J.M.; Arias, C.A. Mechanisms of antibiotic resistance. Microbiol. Spectr. 2016, 4. [Google Scholar] [CrossRef] [PubMed]
- Hall, R.M.; Stokes, H.W. Integrons: Novel DNA elements which capture genes by site-specific recombination. Genetica 1993, 90, 115–132. [Google Scholar] [CrossRef]
- Partridge, S.R. Analysis of antibiotic resistance regions in Gram-negative bacteria. FEMS Microbiol. Rev. 2011, 35, 820–855. [Google Scholar] [CrossRef]
- Whiteley, M.; Diggle, S.P.; Greenberg, E.P. Progress in and promise of bacterial quorum sensing research. Nature 2017, 551, 313–320. [Google Scholar] [CrossRef]
- Kendall, M.M.; Sperandio, V. Quorum sensing by enteric pathogens. Curr. Opin. Gastroenterol. 2007, 23, 10–15. [Google Scholar] [CrossRef]
- Turan, N.B.; Chormey, D.S.; Büyükpınar, Ç.; Engin, G.O.; Bakirdere, S. Quorum sensing: Little talks for an effective bacterial coordination. Trends Analyt. Chem. 2017, 91, 1–11. [Google Scholar] [CrossRef]
- Miller, M.B.; Bassler, B.L. Quorum sensing in bacteria. Annu. Rev. Microbiol. 2001, 55, 165–199. [Google Scholar] [CrossRef]
- Sifri, C.D. Healthcare epidemiology: Quorum sensing: Bacteria talk sense. Clin. Infect. Dis. 2008, 47, 1070–1076. [Google Scholar] [CrossRef]
- Stead, P.; Rudd, B.A.; Bradshaw, H.; Noble, D.; Dawson, M.J. Induction of phenazine biosynthesis in cultures of Pseudomonas aeruginosa by L-N-(3-oxohexanoyl)homoserine lactone. FEMS Microbiol. Lett. 1996, 140, 15–22. [Google Scholar] [CrossRef]
- Bouyahya, A.; Dakka, N.; Et-Touys, A.; Abrini, J.; Bakri, Y. Medicinal plant products targeting quorum sensing for combating bacterial infections. Asian Pac. J. Trop. Med. 2017, 10, 729–743. [Google Scholar] [CrossRef] [PubMed]
- Rasmussen, T.B.; Manefield, M.; Andersen, J.B.; Eberl, L.; Anthoni, U.; Christophersen, C.; Steinberg, P.; Kjelleberg, S.; Givskov, M. How Delisea pulchra furanones affect quorum sensing and swarming motility in Serratia liquefaciens MG1. Microbiology 2000, 146 Pt 12, 3237–3244. [Google Scholar] [CrossRef] [PubMed]
- Federle, M.J.; Bassler, B.L. Interspecies communication in bacteria. J. Clin. Investig. 2003, 112, 1291–1299. [Google Scholar] [CrossRef] [PubMed]
- Pereira, C.S.; Thompson, J.A.; Xavier, K.B. AI-2-mediated signalling in bacteria. FEMS Microbiol. Rev. 2013, 37, 156–181. [Google Scholar] [CrossRef]
- Bassler, B.L.; Greenberg, E.P.; Stevens, A.M. Cross-species induction of luminescence in the quorum-sensing bacterium Vibrio harveyi. J. Bacteriol. 1997, 179, 4043–4045. [Google Scholar] [CrossRef]
- Blair, W.M.; Doucette, G.J. The Vibrio harveyi bioassay used routinely to detect AI-2 quorum sensing inhibition is confounded by inconsistent normalization across marine matrices. J. Microbiol. Methods 2013, 92, 250–252. [Google Scholar] [CrossRef] [PubMed]
- Pellegrini, M.C.; Alvarez, M.V.; Ponce, A.G.; Cugnata, N.M.; De Piano, F.G.; Fuselli, S.R. Anti-quorum sensing and antimicrobial activity of aromatic species from South America. J. Essent. Oil Res. 2014, 26, 458–465. [Google Scholar] [CrossRef]
- Remy, B.; Mion, S.; Plener, L.; Elias, M.; Chabriere, E.; Daude, D. Interference in bacterial quorum sensing: A biopharmaceutical perspective. Front. Pharmacol. 2018, 9, 203. [Google Scholar] [CrossRef]
- Wu, D.; Huang, W.; Duan, Q.; Li, F.; Cheng, H. Sodium houttuyfonate affects production of N-acyl homoserine lactone and quorum sensing-regulated genes expression in Pseudomonas aeruginosa. Front. Microbiol. 2014, 5, 635. [Google Scholar] [CrossRef]
- Lyon, G.J.; Muir, T.W. Chemical signaling among bacteria and its inhibition. Chem. Biol. 2003, 10, 1007–1021. [Google Scholar] [CrossRef][Green Version]
- Vattem, D.A.; Mihalik, K.; Crixell, S.H.; McLean, R.J.C. Dietary phytochemicals as quorum sensing inhibitors. Fitoterapia 2007, 78, 302–310. [Google Scholar] [CrossRef]
- Asfour, H.Z. Anti-quorum sensing natural compounds. J. Microsc. Ultrastruct. 2018, 6, 1–10. [Google Scholar] [CrossRef]
- Yang, M.; Meng, F.; Gu, W.; Li, F.; Tao, Y.; Zhang, Z.; Zhang, F.; Yang, X.; Li, J.; Yu, J. Effects of natural products on bacterial communication and network-quorum sensing. BioMed. Research International. 2020, 2020, 8638103. [Google Scholar] [CrossRef]
- Lu, S.Y.; Zhao, Z.; Avillan, J.J.; Liu, J.; Call, D.R. Autoinducer-2 quorum sensing contributes to regulation of microcin PDI in Escherichia coli. Front. Microbiol. 2017, 8, 2570. [Google Scholar] [CrossRef]
- De Kievit, T.R.; Gillis, R.; Marx, S.; Brown, C.; Iglewski, B.H. Quorum-sensing genes in Pseudomonas aeruginosa biofilms: Their role and expression patterns. Appl. Environ. Microbiol. 2001, 67, 1865–1873. [Google Scholar] [CrossRef]
- Dickschat, J.S. Quorum sensing and bacterial biofilms. Nat. Prod. Rep. 2010, 27, 343–369. [Google Scholar] [CrossRef]
- de la Fuente-Núñez, C.; Korolik, V.; Bains, M.; Nguyen, U.; Breidenstein, E.B.; Horsman, S.; Lewenza, S.; Burrows, L.; Hancock, R.E. Inhibition of bacterial biofilm formation and swarming motility by a small synthetic cationic peptide. Antimicrob. Agents Chemother. 2012, 56, 2696–2704. [Google Scholar] [CrossRef] [PubMed]
- Rasmussen, T.B.; Givskov, M. Quorum-sensing inhibitors as anti-pathogenic drugs. Int. J. Med. Microbiol. 2006, 296, 149–161. [Google Scholar] [CrossRef] [PubMed]
- Chopra, I.; Hodgson, J.; Metcalf, B.; Poste, G. The search for antimicrobial agents effective against bacteria resistant to multiple antibiotics. Antimicrob. Agents Chemother. 1997, 41, 497–503. [Google Scholar] [CrossRef]
- Asenjo, A.; Oteo-Iglesias, J.; Alós, J.I. What’s new in mechanisms of antibiotic resistance in bacteria of clinical origin? Enferm. Infecc. Microbiol. Clin. (Engl Ed) 2021, 39, 291–299. [Google Scholar] [CrossRef] [PubMed]
- Mancuso, G.; Midiri, A.; Gerace, E.; Biondo, C. Bacterial antibiotic resistance: The most critical pathogens. Pathogens 2021, 10, 1310. [Google Scholar] [CrossRef]
- Abudoleh, S.M.; Mahasneh, A.M. Anti-quorum sensing activity of substances isolated from wild berry associated bacteria. Avicenna J. Med. Biotechnol. 2017, 9, 23–30. [Google Scholar]
- Papaneophytou, C.; Giannenas, I.; Dragomir, C. Resistance of bacteria, fungi, and parasites to antibiotics or natural substances of botanical origin. In Feed Additives; Florou-Paneri, P., Christaki, E., Giannenas, I., Eds.; Academic Press: Cambridge, MA, USA, 2020; pp. 339–354. [Google Scholar]
- Pacheco, A.R.; Sperandio, V. Inter-kingdom signaling: Chemical language between bacteria and host. Curr. Opin. Microbiol. 2009, 12, 192–198. [Google Scholar] [CrossRef]
- Keizers, M.; Dobrindt, U.; Berger, M. A simple biosensor-based assay for quantitative autoinducer-2 analysis. ACS Synth. Biol. 2022, 11, 747–759. [Google Scholar] [CrossRef]
- Kjelleberg, S.; Molin, S. Is there a role for quorum sensing signals in bacterial biofilms? Curr. Opin. Microbiol. 2002, 5, 254–258. [Google Scholar] [CrossRef]
- Koh, C.L.; Sam, C.K.; Yin, W.F.; Tan, L.Y.; Krishnan, T.; Chong, Y.M.; Chan, K.G. Plant-derived natural products as sources of anti-quorum sensing compounds. Sensors (Basel) 2013, 13, 6217–6228. [Google Scholar] [CrossRef]
- Poli, J.P.; Guinoiseau, E.; de Rocca Serra, D.; Sutour, S.; Paoli, M.; Tomi, F.; Quilichini, Y.; Berti, L.; Lorenzi, V. Anti-auorum sensing activity of 12 essential oils on chromobacterium violaceum and specific action of cis-cis-p-menthenolide from Corsican Mentha suaveolens ssp. Insularis. Molecules 2018, 23, 2125. [Google Scholar] [CrossRef] [PubMed]
- Xavier, K.B.; Bassler, B.L. Regulation of uptake and processing of the quorum-sensing autoinducer AI-2 in Escherichia coli. J. Bacteriol. 2005, 187, 238–248. [Google Scholar] [CrossRef] [PubMed]
- Hardie, K.R.; Cooksley, C.; Green, A.D.; Winzer, K. Autoinducer 2 activity in Escherichia coli culture supernatants can be actively reduced despite maintenance of an active synthase, LuxS. Microbiology 2003, 149, 715–728. [Google Scholar] [CrossRef] [PubMed]
- Alvarez, M.V.; Ortega-Ramirez, L.A.; Gutierrez-Pacheco, M.M.; Bernal-Mercado, A.T.; Rodriguez-Garcia, I.; Gonzalez-Aguilar, G.A.; Ponce, A.; Moreira, M.d.R.; Roura, S.I.; Ayala-Zavala, J.F. Oregano essential oil-pectin edible films as anti-quorum sensing and food antimicrobial agents. Front. Microbiology 2014, 5. [Google Scholar] [CrossRef]
- Raal, A.; Arak, E.; Orav, A. The content and composition of the essential oil Found in Carum carvi L. commercial fruits obtained from different countries. J. Essent. Oil Res. 2012, 24, 53–59. [Google Scholar] [CrossRef]
- Al-Haidari, R.A.; Shaaban, M.I.; Ibrahim, S.R.M.; Mohamed, G.A. Anti-quorum sensing activity of some medicical plants Afr. J. Tradit. Complement. Altern. Med. 2016, 13, 67–71. [Google Scholar] [CrossRef]
- Szabó, M.Á.; Varga, G.Z.; Hohmann, J.; Schelz, Z.; Szegedi, E.; Amaral, L.; Molnár, J. Inhibition of quorum-sensing signals by essential oils. Phytother. Res. 2010, 24, 782–786. [Google Scholar] [CrossRef]
- Nakagawa, S.; Hillebrand, G.G.; Nunez, G. Rosmarinus officinalis L. (Rosemary) extracts containing carnosic acid and carnosol are potent quorum sensing inhibitors of Staphylococcus aureus virulence. Antibiotics (Basel) 2020, 9, 149. [Google Scholar] [CrossRef]
- Knez Hrnčič, M.; Cör, D.; Simonovska, J.; Knez, Ž.; Kavrakovski, Z.; Rafajlovska, V. Extraction techniques and analytical methods for characterization of active compounds in Origanum species. Molecules 2020, 25, 4735. [Google Scholar] [CrossRef]
- Jakovljević, M.; Jokić, S.; Molnar, M.; Jašić, M.; Babić, J.; Jukić, H.; Banjari, I. Bioactive profile of various Salvia officinalis L. preparations. Plants (Basel) 2019, 8, 55. [Google Scholar] [CrossRef]
- Yeddes, W.; Majdi, H.; Gadhoumi, H.; Affes, T.G.; Mohamed, S.N.; Wannes, W.A.; Saidani-Tounsi, M. Optimizing ethanol extraction of rosemary leaves and their biological evaluations. J. Explor. Res. Pharmacol. 2022, 7, 85–94. [Google Scholar] [CrossRef]
- Dhami, N.; Mishra, A.D. Phytochemical variation: How to resolve the quality controversies of herbal medicinal products? J. Herb. Med. 2015, 5, 118–127. [Google Scholar] [CrossRef]
- Exarchou, V.; Nenadis, N.; Tsimidou, M.; Gerothanassis, I.P.; Troganis, A.; Boskou, D. Antioxidant activities and phenolic composition of extracts from Greek oregano, Greek sage, and summer savory. J. Agric. Food Chem. 2002, 50, 5294–5299. [Google Scholar] [CrossRef] [PubMed]
- Chuang, L.T.; Tsai, T.H.; Lien, T.J.; Huang, W.C.; Liu, J.J.; Chang, H.; Chang, M.L.; Tsai, P.J. Ethanolic extract of Origanum vulgare suppresses propionibacterium acnes-induced inflammatory responses in human monocyte and mouse Ear Edema models. Molecules 2018, 23, 1987. [Google Scholar] [CrossRef]
- Rama Devi, K.; Srinivasan, R.; Kannappan, A.; Santhakumari, S.; Bhuvaneswari, M.; Rajasekar, P.; Prabhu, N.M.; Veera Ravi, A. In vitro and in vivo efficacy of rosmarinic acid on quorum sensing mediated biofilm formation and virulence factor production in Aeromonas hydrophila. Biofouling 2016, 32, 1171–1183. [Google Scholar] [CrossRef]
- Ouyang, J.; Sun, F.; Feng, W.; Sun, Y.; Qiu, X.; Xiong, L.; Liu, Y.; Chen, Y. Quercetin is an effective inhibitor of quorum sensing, biofilm formation and virulence factors in Pseudomonas aeruginosa. J. Appl. Microbiol. 2016, 120, 966–974. [Google Scholar] [CrossRef]
- Xu, W.; Zhang, X.; Wang, L.; Zeng, W.; Sun, Y.; Zhou, C.; Zhou, T.; Shen, M. Effect of chlorogenic acid on the quorum-sensing system of clinically isolated multidrug-resistant Pseudomonas aeruginosa. J. Appl. Microbiol. 2022, 132, 1008–1017. [Google Scholar] [CrossRef]
- Bourhia, M.; Laasri, F.E.; Aourik, H.; Boukhris, A.; Ullah, R.; Bari, A.; Ali, S.S.; El Mzibri, M.; Benbacer, L.; Gmouh, S. Antioxidant and antiproliferative activities of bioactive compounds contained in Rosmarinus officinalis used in the mediterranean diet. Evid. Based Complement. Alternat. Med. 2019, 2019, 7623830. [Google Scholar] [CrossRef]
- Ollanketo, M.; Peltoketo, A.; Hartonen, K.; Hiltunen, R.; Riekkola, M.-L. Extraction of sage (Salvia officinalis L.) by pressurized hot water and conventional methods: Antioxidant activity of the extracts. Eur. Food Res. Technol. 2002, 215, 158–163. [Google Scholar] [CrossRef]
- Lu, L.; Hu, W.; Tian, Z.; Yuan, D.; Yi, G.; Zhou, Y.; Cheng, Q.; Zhu, J.; Li, M. Developing natural products as potential anti-biofilm agents. Chinese Med. 2019, 14, 11. [Google Scholar] [CrossRef]
- Singh, V.K.; Mishra, A.; Jha, B. Anti-quorum sensing and anti-biofilm activity of Delftia tsuruhatensis extract by attenuating the quorum sensing-controlled virulence factor production in Pseudomonas aeruginosa. Front. Cell.Infect. Microbiol. 2017, 7, 337. [Google Scholar] [CrossRef] [PubMed]
- Hacioglu, M.; Oyardi, O.; Kirinti, A. Oregano essential oil inhibits Candida spp. biofilms. Z. Naturforsch. C J. Biosci. 2021, 76, 443–450. [Google Scholar] [CrossRef] [PubMed]
- Bilge, N.; Vatansever, L.; Duman, B.; Sezer, Ç.; Guven, A.; Gulmez, M.; Baser, K.H.C.; Kurkcuoglu, M. Effect of oregano essential oil on biofilms formed by Staphylococci and Escherichia coli. Kafkas Univ. Vet. Fak. Derg. 2010, 16, 23–29. [Google Scholar]
- de Oliveira, J.; Jesus, D.; Oliveira, L. Rosmarinus officinalis L. (Rosemary) extract decreases the biofilms viability of oral health interest. Braz. Dent. Sci. 2017, 20, 64–69. [Google Scholar] [CrossRef]
- Selim, S.; Almuhayawi, M.S.; Alqhtani, H.; Al Jaouni, S.K.; Saleh, F.M.; Warrad, M.; Hagagy, N. Anti-Salmonella and antibiofilm potency of Salvia officinalis L. essential oil against antibiotic-resistant Salmonella enterica. Antibiotics (Basel) 2022, 11, 489. [Google Scholar] [CrossRef]
- Stojanović-Radić, Z.; Pejcić, M.; Stojanović, N.; Sharifi-Rad, J.; Stanković, N. Potential of Ocimum basilicum L. and Salvia officinalis L. essential oils against biofilms of P. aeruginosa clinical isolates. Cell. Mol. Biol. 2016, 62, 27–33. [Google Scholar]
- Pratt, L.A.; Kolter, R. Genetic analysis of Escherichia coli biofilm formation: Roles of flagella, motility, chemotaxis and type I pili. Mol. Microbiol. 1998, 30, 285–293. [Google Scholar] [CrossRef]
- Kearns, D.B. A field guide to bacterial swarming motility. Nat. Rev. Microbiol. 2010, 8, 634–644. [Google Scholar] [CrossRef]
- Issac Abraham, S.V.P.; Palani, A.; Ramaswamy, B.R.; Shunmugiah, K.P.; Arumugam, V.R. Antiquorum sensing and antibiofilm potential of Capparis spinosa. Arch. Med. Res. 2011, 42, 658–668. [Google Scholar] [CrossRef]
- Noumi, E.; Snoussi, M.; Merghni, A.; Nazzaro, F.; Quindós, G.; Akdamar, G.; Mastouri, M.; Al-Sieni, A.; Ceylan, O. Phytochemical composition, anti-biofilm and anti-quorum sensing potential of fruit, stem and leaves of Salvadora persica L. methanolic extracts. Microb. Pathog. 2017, 109, 169–176. [Google Scholar] [CrossRef] [PubMed]
- Khan, M.S.; Zahin, M.; Hasan, S.; Husain, F.M.; Ahmad, I. Inhibition of quorum sensing regulated bacterial functions by plant essential oils with special reference to clove oil. Lett. Appl. Microbiol. 2009, 49, 354–360. [Google Scholar] [CrossRef] [PubMed]
- Govindaraghavan, S.; Sucher, N.J. Quality assessment of medicinal herbs and their extracts: Criteria and prerequisites for consistent safety and efficacy of herbal medicines. Epilepsy Behav. 2015, 52, 363–371. [Google Scholar] [CrossRef] [PubMed]
- Chemat, F.; Vian, M.A.; Cravotto, G. Green extraction of natural products: Concept and principles. Int. J. Mol. Sci. 2012, 13, 8615–8627. [Google Scholar] [CrossRef] [PubMed]
- Surette, M.G.; Bassler, B.L. Regulation of autoinducer production in Salmonella typhimurium. Mol. Microbiol. 1999, 31, 585–595. [Google Scholar] [CrossRef]
- Surette, M.G.; Bassler, B.L. Quorum sensing in Escherichia coli and Salmonella typhimurium. Proc. Natl. Acad. Sci. USA 1998, 95, 7046–7050. [Google Scholar] [CrossRef]
- Bassler, B.L.; Wright, M.; Silverman, M.R. Multiple signalling systems controlling expression of luminescence in Vibrio harveyi: Sequence and function of genes encoding a second sensory pathway. Mol. Microbiol. 1994, 13, 273–286. [Google Scholar] [CrossRef]
- Girennavar, B.; Cepeda, M.L.; Soni, K.A.; Vikram, A.; Jesudhasan, P.; Jayaprakasha, G.K.; Pillai, S.D.; Patil, B.S. Grapefruit juice and its furocoumarins inhibits autoinducer signaling and biofilm formation in bacteria. Int. J. Food Microbiol. 2008, 125, 204–208. [Google Scholar] [CrossRef]
- Merritt, J.H.; Kadouri, D.E.; O’Toole, G.A. Growing and analyzing static biofilms. Curr. Protoc. Microbiol. 2006, 1B.1.1–1B.1.17. [Google Scholar] [CrossRef]
- Manner, S.; Fallarero, A. Screening of natural product derivatives identifies two structurally related flavonoids as potent quorum sensing inhibitors against gram-negative bacteria. Int. J. Mol. Sci. 2018, 19, 1346. [Google Scholar] [CrossRef]
- Quave, C.L.; Plano, L.R.W.; Pantuso, T.; Bennett, B.C. Effects of extracts from Italian medicinal plants on planktonic growth, biofilm formation and adherence of methicillin-resistant Staphylococcus aureus. J. Ethnopharmacol. 2008, 118, 418–428. [Google Scholar] [CrossRef]

| Scientific Name | Common Name | Family | Extraction Yield (% Dry Mass) | Extract Color Intensity 1 |
|---|---|---|---|---|
| Origanum vulgare subsp. hirtum | Oregano | Lamiaceae | 13.92 | + |
| Rosmarinus officinalis | Rosemary | Lamiaceae | 30.61 | + |
| Salvia officinalis | Common sage | Lamiaceae | 23.37 | +++ |
| Lavendula spp | Lavender | Lamiaceae | 9.25 | ++ |
| Calendula officinalis | Calendula | Asteraceae | 18.32 | ++ |
| Melissa officinalis | Lemon balm | Lamiaceae | 12.98 | ++++ |
| Sideritis cypria | Cyprian sideritis | Lamiaceae | 14.87 | ++++ |
| Aloysia citriodora | Lemon beebrush | Verbenaceae | 7.20 | +++ |
| Compound | HPLC Retention Time (min) | ESI-MS [M + H] +, Da | Plant |
|---|---|---|---|
| Quercetin | 16.3 | 303.044929 | Oregano Rosemary Common sage |
| Chlorogenic Acid | 20.3 | 335.1022359 | Oregano Rosemary Common sage |
| Carnosol | 25.6 | 331.190386 | Oregano Rosemary Common sage |
| Apigenin | 15.2 | 271.0601 | Oregano |
| Rosmarinic acid | 16.7 | 361.091794 | Oregano |
Publisher’s Note: MDPI stays neutral with regard to jurisdictional claims in published maps and institutional affiliations. |
© 2022 by the authors. Licensee MDPI, Basel, Switzerland. This article is an open access article distributed under the terms and conditions of the Creative Commons Attribution (CC BY) license (https://creativecommons.org/licenses/by/4.0/).
Share and Cite
Panayi, T.; Sarigiannis, Y.; Mourelatou, E.; Hapeshis, E.; Papaneophytou, C. Anti-Quorum-Sensing Potential of Ethanolic Extracts of Aromatic Plants from the Flora of Cyprus. Plants 2022, 11, 2632. https://doi.org/10.3390/plants11192632
Panayi T, Sarigiannis Y, Mourelatou E, Hapeshis E, Papaneophytou C. Anti-Quorum-Sensing Potential of Ethanolic Extracts of Aromatic Plants from the Flora of Cyprus. Plants. 2022; 11(19):2632. https://doi.org/10.3390/plants11192632
Chicago/Turabian StylePanayi, Tolis, Yiannis Sarigiannis, Elena Mourelatou, Evroula Hapeshis, and Christos Papaneophytou. 2022. "Anti-Quorum-Sensing Potential of Ethanolic Extracts of Aromatic Plants from the Flora of Cyprus" Plants 11, no. 19: 2632. https://doi.org/10.3390/plants11192632
APA StylePanayi, T., Sarigiannis, Y., Mourelatou, E., Hapeshis, E., & Papaneophytou, C. (2022). Anti-Quorum-Sensing Potential of Ethanolic Extracts of Aromatic Plants from the Flora of Cyprus. Plants, 11(19), 2632. https://doi.org/10.3390/plants11192632

